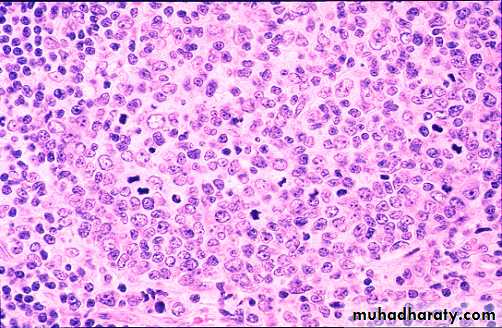
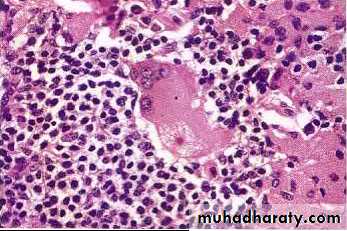

Pathology of Lymph Nodes
DR.HAMEED N.MOUSA F.I.C.M.S PATHOLOGYAs with other organs, lymph nodes, and more globally, the immune system, can be the site of infectious, immune and neoplastic disease, the latter either primary or metastatic
The clinical manifestations of diseases of the lymph nodes are:
Local enlargement, tender on nontender, +/_
Compression of adjacent structures +/_
Release of cytokines producing "systemic" symptoms of fever, weight loss and night sweats
Infectious organisms can stimulate the same acute, chronic or granulomatous reactions in the draining lymph nodes as they characteristically stimulate at other sites
Several types of immune stimuli can cause "reactive" enlargement of the entire lymph node, or selective expansion of cortical, paracortical or medullary regions
Metastatic tumors spread to the lymph nodes primarily via lymphatic drainage from adjacent solid organs
Primary neoplasms of the lymph nodes are all malignant
They are divided into malignant non-Hodgkin's lymphomas (NHL), and Hodgkin lymphoma
NHL's are more common, and can be simply divided into indolent, or slow growing types, and aggressive types
Malignant lymphomas represent clonal malignancies in which mutational events have caused the majority of progeny cells to freeze at a single stage of normal lymphocyte differentiation
Lymphomas frozen at a stage associated with high replication --> aggressive lymphomas;
Lymphomas frozen at stages associated with recirculation or final function --> indolent lymphomas
The diagnosis of malignant lymphomas is based on the microscopic recognition of the dominant cytologic cell type, supplemented by immunologic and molecular techniques
The treatment and prognosis of lymphomas are based on
The dominant cell type (and it's inherent biologic behavior),
The extent of spread (Stage)
The underlying health of the patient
All of the previous statements are complicated by the fact that indolent lymphomas can further mutate and transform to aggressive types
Hodgkin lymphoma is a less common nodal disease whose diagnosis is based on the detection of a characteristic cell, the Reed Sternberg cell, in the appropriate histologic setting
There are several (five) histologic subtypes, but prognosis is based primarily on extent of disease
Hodgkin lymphoma is a more curable disease than non-Hodgkin lymphomas
Now watch me confuse this relatively straightforward information with the details.
Lymph node evaluation
BiopsySelection of the lymph node to be biopsied is of great
importance. Inguinal nodes are to be avoided whenever
possible because of the high frequency of chronic inflammatory and fibrotic changes present in them
. Axillary or cervical nodes are more likely to be informative in cases of generalized lymphadenopathy
. Whenever possible,
the largest lymph node in the region should be biopsied.Small superficial nodes may show only nonspecific
hyperplasia, whereas a deeper node of the same group
may show diagnostic features.
Bacteriologic examination
If there is a possibility that the node contains an infectious
process, an adequate sample of the biopsied lymph
node must be sent directly for bacteriologic study or at
least be placed in a sterile Petri dish in the refrigerator
Needle biopsy
Core needle biopsy is adequate for the diagnosis of
metastatic carcinoma but is rarely used for the evaluation
of primary lymphoid disorders.
DNA ploidy studies
Examination of DNA ploidy by flow cytometry of cellsuspensions from fluids or material from fine needle
aspiration or from tissue sections has shown a good
correlation with the microscopic grades of malignant lymphoma
,
Overview of the lymphoid immune system
• Lymphocytes evolve from pluripotent stem cells --> two major functional cell types:B lymphocytes, comprising the humoral immune --> production of antibodies
T lymphocytes, comprising the cellular immune system, -->
Direct killing of foreign or intracellularly infected cells, cytotoxic T cells
Fine control of the immune response through the secretion of cytokines, helper and suppressor T cells.
Both cortex and medulla
represent B zones and are therefore associated
with humoral types of immune response
The paracortex is the zone situated between the cortex
and the medulla, which contains the mobile pool of T
lymphocytes responsible for cell-mediated. immune
response
Lymph node anatomy
To recognize lymph node pathology, one has to be familiar with normal lymph node anatomy and cytologyLymph node histology
Lymph node variation
Lymph node histology is dynamic: folliclesIn the absence of immune stimulation, primary follicles
In the presence of immune stimulation, secondary follicles or germinal centers
Reactive germinal center
MZ
LZ
DZ
Pathology of lymph nodes
Infections
Reactive hyperplasias
Sarcoidosis
Metastatic tumors
Malignant lymphomas
Non-Hodgkin’s lymphoma-NHL
Hodgkin’s lymphoma
Pathology of lymph nodes
InfectionsBacterial
Acute inflammation, abscess formation
Granulomatous, caseous and noncaseous
Diagnosis by culture, serologies, and/or special stains
Large adherent tuberculous
lymph nodes containing extensive fociof caseation necrosis.
Numerous confluent non-necrotizing granulomas mainly
composed of epithelioid cells in a lymph node affected bysarcoidosis
Asteroid body in the cytoplasm of a multinucleated
giant cell in sarcoidosisReactive hyperplasias
Exaggerations of normal histology.Expansion of all regions or selective expansion
Some types characteristic of certain diseases, but most not
Follicular hyperplasia- increase in number and size of germinal centers, spread into paracortex, medullary areas
Collagen vascular diseases
Systemic toxoplasmosis
Syphillis
Interfollicular hyperplasia- paracortex
Skin diseases
Viral infections
Drug reactions
Sinus histiocytosis- expansion of the medullary sinus histiocytes-
Adjacent cancer
Infections